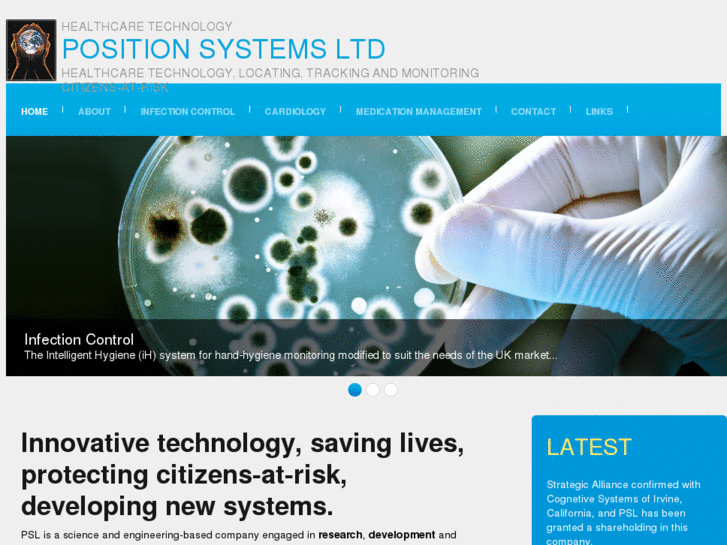

| POSITION-SYSTEMS.COM преглед на сайт :. |
|
| POSITION-SYSTEMS.COM преглед на сайт :. |
|
Картинката на сайта 'position-systems.com' е ганерирана на June 09 2011 10:59 |
| Уеб сайтове Домейн имена ИП адреси Домейни от първо ниво | Copyright © 2025 bgwhois.com |